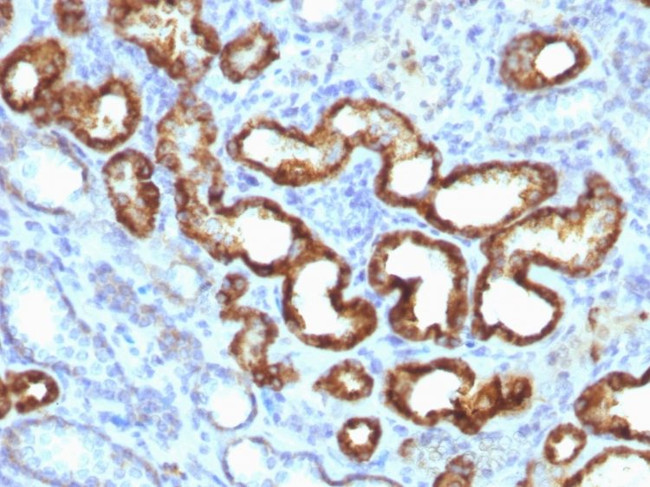
AMACR/p504S (Prostate Cancer Marker) Antibody in Immunohistochemistry (Paraffin) (IHC (P))

Search
NeoBiotechnologies
AMACR/p504S (Prostate Cancer Marker) Recombinant Rabbit Monoclonal Antibody (13H4)
{{$productOrderCtrl.translations['antibody.pdp.commerceCard.promotion.promotions']}}
{{$productOrderCtrl.translations['antibody.pdp.commerceCard.promotion.viewpromo']}}
{{$productOrderCtrl.translations['antibody.pdp.commerceCard.promotion.promocode']}}: {{promo.promoCode}} {{promo.promoTitle}} {{promo.promoDescription}}. {{$productOrderCtrl.translations['antibody.pdp.commerceCard.promotion.learnmore']}}
产品信息
23600-RBM1-P1
种属反应
宿主/亚型
Expression System
分类
类型
克隆号
抗原
偶联物
形式
浓度
规格
纯化类型
保存液
内含物
保存条件
运输条件
产品详细信息
Antibody is stable for 24 months.
Positive Control: HEK cells. Human kidney or prostate adeno carcinoma. Cellular Localization: Cytoplasm
Specificity Comments: This antibody recognizes a protein of 54kDa, which is identified as AMACR, also known as p504S. It is an enzyme that is involved in bile acid biosynthesis and -oxidation of branched-chain fatty acids. AMACR is essential in lipid metabolism. It is expressed in cells of premalignant high-grade prostatic intraepithelial neoplasia (HGPIN) and prostate adeno carcinoma. The majority of the carcinoma cells show a distinct granular cytoplasmic staining reaction. AMACR is present at low or undetectable levels in glandular epithelial cells of normal prostate and benign prostatic hyperplasia. A spotty granular cytoplasmic staining is seen in a few cells of the benign glands. AMACR is expressed in normal liver (hepatocytes), kidney (tubular epithelial cells) and gall bladder (epithelial cells). Expression has also been found in lung (bronchial epithelial cells) and colon (colonic surface epithelium). AMACR expression can also be found in hepatocellular carcinoma and kidney carcinoma. Past studies have also shown that AMACR is expressed in various colon carcinomas (well, moderately and poorly differentiated) and over expressed in prostate carcinoma.
靶标信息
P504S/AMACR/a-Methylacyl-CoA Racemase is an essential enzyme in the b-oxidation of branched-chain fatty acids. High expression of P504S protein is found in prostatic adenocarcinoma but not in benign prostate tissue by immunohistochemical staining in paraffin-embedded tissue. The expression of P504S is also detected in two premalignant lesions of the prostate: high-grade prostatic intraepithelial neoplasia (PIN) and atypical adenomatous hyperplasia.
仅用于科研。不用于诊断过程。未经明确授权不得转售。
篇参考文献 (0)
生物信息学
蛋白别名: 2-methylacyl-CoA racemase; Alpha-methylacyl-CoA racemase; AMACR; AMACRIADEL; amcr; OTTHUMP00000219978; OTTHUMP00000219979; unnamed protein product
基因别名: AMACR; AMACRD; CBAS4; P504S; RACE; RM
UniProt ID: (Human) Q9UHK6
Entrez Gene ID: (Human) 23600